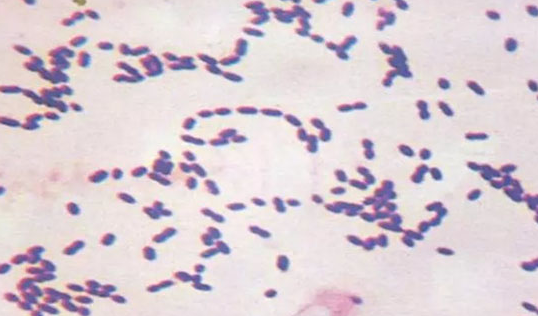
1755314156133.png 1755314156133.png

警惕!高溫天氣豬鏈球菌病來襲,這些癥狀要當心!
鏈球菌病(streptococosis)主要是由β溶血性鏈球菌引起的多種人獸共患病的總稱。動物鏈球菌病中以豬、牛、羊、馬、雞較常見,人鏈球菌病以猩紅熱較多見。鏈球菌病的臨床表現多種多樣,既可以引起各種化膿創,也能引起敗血癥。
病 原
鏈球菌:本菌呈圓形或卵圓形,常排列成鏈,鏈的長短不一,也可單個或成雙存在。革蘭染色陽性,多數鏈球菌無鞭毛。
流行病學
豬、牛、羊、雞等均有易感性,豬不分年齡、品種和性別均易感。豬鏈球菌病以7-10月份易出現大面積流行。患病和病死動物是主要傳染源,帶菌動物也是傳染源。仔豬多由母豬傳染而引起。本菌主要經呼吸道和受損的皮膚及黏膜感染。
豬鏈球菌病的臨床癥狀及病理變化
臨床上主要以淋巴結膿腫、腦膜炎、關節炎以及敗血癥為主要特征。
超急性病例,病豬不表現任何癥狀即突然死亡。急性病例中的臨床癥狀主要是發熱、抑郁、厭食,隨后表現一種或幾種以下癥狀,如共濟失調、震顫發抖、角弓反張、失明、聽覺喪失、麻痹、呼吸困難、驚厥、關節炎、跛行、流產、心內膜炎、陰道炎等。
超急性和急性感染豬鏈球菌而引起死亡的豬通常沒有肉眼可見的病變,部分表現為腦膜炎的病豬可見腦脊膜、淋巴結及肺充血。在關節炎的病例中,最早見到的變化是滑膜血管的擴張和充血,關節表面可能出現纖維蛋白性多發性漿膜炎。
心臟損害包括纖維蛋白性化膿性心包炎、機械性心瓣膜心內膜炎、出血性心肌炎。豬鏈球菌感染普遍引起肺臟實質性病變,包括纖維素出血性和間質纖維素性肺炎、纖維素性或化膿性支氣管肺炎。因從豬鏈球菌感染的病豬肺內常分離出多殺性巴氏桿菌、胸膜肺炎放線桿菌等細菌,故部分學者認為病豬肺部的病變可能與以上細菌的繼發感染有關。另外,豬鏈球菌還可以引起豬的敗血癥。全身臟器往往會出現充血或出血現象。
診 斷
根據臨床癥狀和病理變化,再結合流行病學特點可做出初步診斷,確診需進行實驗室檢查,包括細菌學檢查(染色鏡檢),培養檢查(血液瓊脂培養基)和動物接種。
防 控
1、免疫接種對預防和控制本病傳播效果顯著。
2、應用抗菌藥物治療有效。當分離出致病鏈球菌后,應立即進行藥敏試驗。根據試驗結果,選出特效藥物進行全身治療。給藥推薦藥物有50%阿莫西林可溶性粉/80%阿莫西林可溶性粉、復方阿莫西林粉、10%(50%)鹽酸多西環素可溶性粉、20%氟苯尼考粉、20%替米考星預混劑等。牛、羊、豬注射可用注射用鹽酸頭孢噻呋、硫酸頭孢喹肟注射液。
安力素(80%阿莫西林可溶性粉)
安力健(復方阿莫西林粉)
3、局部治療可先將潰爛組織剝離,膿腫應予切開,清除膿汁,清洗和消毒。然后用抗生素以懸液、軟膏或粉劑置人患處。必要時可施以包扎。
4、在養殖場,平時應建立和健全消毒、隔離制度。保持舍清潔、干燥及通風,經常清除糞便,定期更換墊草,保持地面清潔。引進動物時必須經檢疫和隔離觀察,確證健康時方能混群飼養。
5、發現疫情時應立即采取緊急防控措施:盡快確診,制定緊急防控辦法,劃定疫點、疫區,隔離患病動物,封鎖疫區。對被污染的圈舍、用具進行消毒后,再進行徹底清洗、干燥。糞便和褥草堆積發酵。對假定健康群動物可應用抗菌藥物作預防性治療或用疫苗作緊急接種。患病或病死豬是本病的主要傳染源,因此應嚴格禁止擅自宰殺和自行處理,必須在獸醫監督下,一律送到指定屠宰場,按屠宰條例有關規定處理。
6、警惕鏈球菌感染人。有傷口的人避免接觸病豬或死豬。
上一篇:籠養肉雞夏季通風方案





